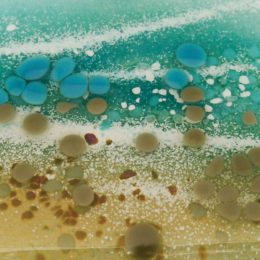
Abstract Sea

Fused glass handmade by fused glass artist Stephanie O'Brien. Bespoke fused glass art, splashbacks, unique fused glass wall art, original bowls, coasters and much more!
T (01695) 624182
Email: info@morpheusglass.co.uk
Morpheus Glass
Love it Gallery, Winstanley Road, Billinge, Wigan, Lancashire, WN5 7XG